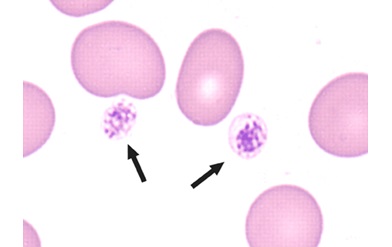

Antiplatelet Therapy
This article was published in December 2008 as part of the special ASH anniversary brochure, 50 Years in Hematology: Research That Revolutionized Patient Care.
Once thought to be just "dust" particles in blood, platelets were first recognized as a special class of blood cells (actually cell fragments) by an Italian researcher in 1882. Hematology research over the past century has subsequently unraveled what platelets normally do, why they can cause cardiovascular disease under certain conditions, and how they can be effectively targeted with antiplatelet therapy to prevent and treat heart attacks and stroke.
We now know that platelets are born in the bone marrow, from which they are released into circulating blood. At any given time, the blood of an average adult carries over a trillion platelets throughout his or her body, each one surviving for about a week before being replenished by new platelets arising in the marrow. Platelets are like microscopic circulating band-aids, constantly looking for leaks in the vascular system and then instantaneously plugging these bleeding sites by sticking to the wound (a process called adhesion), becoming activated locally, and then attracting other circulating platelets to build an impermeable clump (a process called aggregation) at the exact point of damage. This protective mechanism, which is a desirable function of platelets, is called hemostasis. But under some conditions platelets can become harmful, causing plugs to form where there is no bleeding and they are not needed. This typically happens in arteries that have become diseased with atherosclerosis, a condition in which deposits of fat or plaque collect and harden in the arteries, blocking the normal flow of blood. Platelets can stick to atherosclerotic plaques in the coronary and brain arteries and obstruct, or occlude, these vessels causing heart attacks and strokes. This undesirable, pathological process is called thrombosis.
It was first noted more than 50 years ago by a private practitioner that aspirin, which had been used in its native form since antiquity to treat fever and pain, was remarkably able to protect individuals from heart attacks. The ability of aspirin to prevent cardiovascular disease was subsequently found by hematologists to be due to its effects on platelets. Beginning in the mid-1960s, several investigators conducted basic hematology research to clearly identify the precise mechanism by which aspirin inhibits platelet activation and aggregation. Aspirin thus became the first effective antiplatelet drug. It is still in wide use today to prevent cardiovascular complications that are caused by pathological platelet occlusion of atherosclerotic arteries.
Understanding exactly how aspirin blocks platelets demonstrated the power of hematology research in translating observations made by physicians in their practice to basic science mechanisms ("bedside to bench" research). In subsequent years, hematologists discovered the precise sequence of molecular events that normally occur to instantaneously transform an inactive, circulating platelet to one that sticks to and aggregates with other platelets on the inside surface of a diseased vessel wall. This basic knowledge, in turn, has permitted the development of new antiplatelet drugs to target one or more of these molecular events.
Based on fundamental hematology research that defined the mechanisms of platelet aggregation, an American hematologist developed the next clinically effective antiplatelet agent, a monoclonal antibody against the platelet membrane protein that initiates aggregation (the glycoprotein (GP) IIb/IIIa complex). This drug (abciximab) was approved by the FDA in 1994 to reduce the thrombotic complications of coronary angioplasty. Other GP IIb/IIIa receptor antagonists soon followed, and this class of drugs is now in wide use to also treat acute coronary syndromes.
Yet another class of antiplatelet drugs called ADP receptor antagonists (ticlopidine, clopidogrel) were first found in 1998 to greatly reduce the occlusion of coronary stents (devices placed inside an atherosclerotic artery to hold it open and prevent further narrowing), a particularly thrombosis-provoking intervention. These new antiplatelet drugs may have wider application in the prevention of vascular disease by improving on or adding to the beneficial actions of aspirin.
Thus, basic hematology research to understand how platelets work and how their function can be blocked has transformed our modern approach to the prevention and treatment of cardiovascular disease. Excessive interference with platelet function with any of these antiplatelet agents carries with it the risk of causing the opposite of thrombosis, namely bleeding complications. To provide optimal protection from thrombosis with no risk of bleeding will be the next frontier of hematology research in antiplatelet therapy. It will require the identification of agents that can selectively block undesired, pathological thrombosis without interfering with physiologically protective hemostasis.